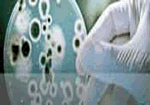

| » BROJ 45 |
 |
Godina IX
Mart - April 2011.
|
|
| » Br. 45 Glavni naslovi |
 MEDICINA MEDICINA
Dr Ivana Marković
Estetska stomatologija
Lepši osmeh za jedan dan
Estetika zuba i vilice, pa time i lica, značajno se može korigovati različitim tehnikama, konzervativnim, protetskim ili ortodontskim. O najsavremenijim protetskim procedurama u kojima se primenjuje bezmetalna keramika govori dr Ivana Marković, stomatolog u Opštoj bolnici Bel Medic.
Zdravlje usta i zuba je prevashodni cilj i osnovno polje interesovanja stomatologije, ali se danas ova grana medicine sve više bavi i estetskom rehabilitacijom zuba. Slično kao estetska hirurgija kad je reč o licu i telu, estetska stomatologija takođe ima moć da pomogne osobi koja je nezadovoljna svojim izgledom, time što će ulepšati nešto što na poseban način doprinosi lepoti i šarmu, a to je - osmeh
| Pripremila: Gordana Tomljenović |
Tekst |
|
 MEDICINA MEDICINA
Dr Aleksandra Petrović
Interna medicina
Piramida medicinskog znanja
Medicinska specijalnost koja se bavi dijagnostikovanjem, lečenjem i prevencijom oboljenja i stanja kod odraslih, koja ne zahtevaju hirurško zbrinjavanje, vrlo je raznolika. Dr Aleksandra Petrović, internista u Bel Medic-u, kaže da je vrlo često u prilici da rešava medicinske „zagonetke“ baš zbog činjenice da opšta interna medicina poznaje širok raspon oboljenja i njihovih uzročnika, od hepatitisa do kancera.
Izraz „medicinska specijalnost“ za laike obično znači da je reč o poznavanju nekog užeg polja medicine, koje se bavi jednim organskim sistemom. Opšta interna medicina je, međutim, široka medicinska specijalnost koja bi se mogla opisati kao mozaik sastavljen od niza internističkih subspecijalnosti - endokrinologije, kardiologije, pulmologije, alergologije, gastroenterologije, nefrologije, hematologije, reaumatologije, onkologije...
|
 FIZIKA FIZIKA
Objedinjeni institut za nuklearna istraživanja u Dubni
Naučni gigant sa obale Volge
Severno od Moskve , na obalama Volge leži gradić Dubna . U njemu se nalazi se jedan od najznačajnijih svetskih naučnih centara : Objedinjeni institut za nuklearna istraživanja . Fizičari iz Dubne su uradili mnogo prvorazrednih otkrića i za svoj rad dobili brojne međunarodne i nacionalne nagrade . Od četrdesetak otkrića iz oblasti nuklearne fizike registrovanih u SSSR , polovina pripada fizičarima iz ove institucije . Naučna zajednica je odala priznanje ovoj instituciji tako što je transuranskom elementu sa rednim brojem 105, koji je sintetisan u ovom institutu , dodelila naziv dubnijum
| Pripremio: D. Čevizović |
Tekst |
|
 TEHNOLOGIJE TEHNOLOGIJE
Desalinizacija morske vode
Preko vakuuma do pitke vode
Tri četvrtine Zemljine površine prekriveno je vodom. Od toga, na mora i okeane, tj. na slanu vodu otpada preko 97,5 %, a na slatkovodne rezerve tek 2,5%. Ako se tih 2,5% umanje za iznos slatkih voda koje se nalaze pod lednicima i pod snežnim pokrivačem, ostaje jedva 0,8% voda koje se neophodne za život na Zemlji
| Pripremio:Jozef Baruhović |
Tekst |
|
 SAOBRAĆAJ SAOBRAĆAJ
Leteći automobili
Mašina za drum i nebo
Leteći automobili ili letelice koje se mogu kretati konvencionalnim drumom, predmet su interesovanja ljudi gotovo od kako su oba sredstva i izmisljena. Zahvaljujući napretku tehnologije, ovakva vozila se već u veoma bliskoj budućnosti mogu očekivati na našim drumovima i iznad naših glava
| Pripremio: Darko Mladenović |
Tekst |
|
 NAUKA KAO ŽIVOT NAUKA KAO ŽIVOT
Akademik Miljenko Perić, redovni profesor Fakulteta za fizičku hemiju Univerziteta u Beogradu
Netačni računi (bez) vrednih molekula
Akademik Miljenko Perić (1949), redovni profesor Fakulteta za fizičku hemiju (Kvantna hemija i molekulske strukture, Spektri i strukture ), najmlađa je zvezda u sazvežđu znamenitih fizikomičara Beogradskog univerziteta. Taj skup čine njegovi slavni prethodnici : Miloje Stojiljković , utemeljivač fizičkohemijskih studija Šsamo šesnaest godina pošto je fizička hemija ozvaničena kao nova nauka (Zeitschrift f ü r Physikalische Chemie, Leipzig, 1887) Ć , Pavle Savić , Slobodan Ristić , Slobodanka Veljković , Milenko Šušić , Slobodan Ribnikar, ali i profesori Tehnološkog fakulteta ( N. Pušin , P . Tutundžić, A.Despić , M . Ristić ). Većina su bili časnici Srpske akademije , Pavle Savić i Aleksandar Despić i njeni čelnici. Miljenko Perić je prvi kvantni hemičar kome je SANU otvorila svoja vrata
| Pripremio: Miloslav Rajković |
Tekst |
|
 ARHITEKTURA ARHITEKTURA
Lord Norman Foster
U službi nauke i ekologije
Autor najvećih objekata arhitekture u svetu, od Londona do Hong Konga, od SAD do Evrope, lord Norman Foster, briljantnu karijeru ostvario je uz tim u Londonu sa više stotina saradnika u svetu i velikim brojem firmi sa kojima sarađuje.
Fosterova arhitektura osvetljena je prirodnom svetlošću i ostvaruje vizuelni kontakt sa okruženjem i zelenilom. Ogromne konstrukcije žive i dišu, vazduh kroz njih prirodno kruži u zavisnosti od toplote koju sprovodi kako bi dobio optimalne performanse grejanja i energetske efikasnosti.
| Pripremio: Mirjana Lukić |
Tekst |
|
 ASTROFIZIKA ASTROFIZIKA
Nastanak galaksije
Zemlja nije izuzetak
Posle Velikog praska, gustina elementarnih čestica (neutrona, protona, elektrona...) koje su haotično ispunjavale sav prostor nije dozvoljavala svetlosti da se probije tako da je svuda u ranoj vasioni vladala tama. Daljim razvojem materije stvorili su se uslovi za probijanje elektromagnetnih talasa (svetlosti) koji se i sada opažaju u vidu reliktnog pozadinskog zračenja
| Pripremio: Zoran Janjušević |
Tekst |
|
 SVETSKA BAŠTINA SVETSKA BAŠTINA
Volubilis
RaskoŠ antiČkog zapada
Drevni antički grad Volubilis (arapski:Valili) danas je najveće arheološko nalazište u Maroku i najbolje očuvani grad iz vremena Rimskog carstva. Nalazi su na severozapadu Afrike, u kontinentalnom delu, udaljen par kilometara od Mulej Idrisa, prvog islamskog grada u tom delu Maroka. Godine 1997. upisan je na UNESCO-vu listu svetske kulturne baštine
|
 HOBI HOBI
Maketarstvo
Mali veliki svet
Prvi otkriveni modeli i makete potiču iz drevnog Egipta, a minijaturni modeli kočija i brodova, kakvi su se mogli videti na Nilu u to vreme, pronađeni su prilikom arheoloških istraživanja faraonskih grobnica. Makete jedrenjaka koje datiraju iz vremena Napoleonovih ratova a koje su izrađivali zarobljenici i danas predstavljaju maketarske dragulje
| Pripremio: Darko Mladenović |
Tekst |
|
 TEMA BROJA - MOLEKULARNA BIOLOGIJA TEMA BROJA - MOLEKULARNA BIOLOGIJA
U Srbiji danas
Kanazirovo zaveštanje
U publikaciji pod nazivom “Zaveštanja” Dušan T. Kanazir je detaljno prikazao svoj dvadesettrogodišnji rad u SANU i drugim društvenim institucijama. Ovom prilikom, kada u magazinu koji ima za cilj da populariše nauku, pre svega nauku u Srbiji i njene naučnike, i kada temu broja posvećujemo molekularnoj biologiji, čini se da čitavu ovu biološku disciplinu možemo sagledati kao Kanazirovo naučno zaveštanje. On je njen začetnik, njemu pripadaju najveće zasluge za njen razvoj, koji je usmeravao ukorak sa svetom, i osnivanje studijske grupe za molekularnu biologiju i fiziologiju na PMF Univerziteta u Beogradu |
 TEMA BROJA - MOLEKULARNA BIOLOGIJA TEMA BROJA - MOLEKULARNA BIOLOGIJA
Molekularna biotehnologija
Ligamenti od biočelika
Molekularna biotehnologija je nova naučna disciplina zasnovana na mogućnostima prenosa specifične jedinstvene genske informacije iz jednog organizma u drugi korišćenjem genetičkog inženjerstva - kaže dr Ljubiša Topisirović, profesor Dinamičke biohemije na Biološkom fakultetu u Beogradu i direktor Instituta za molekularnu genetiku i genetičko inženjerstvo. Ili, grubo rečeno: proces koji koristi žive organizme ili njihove delove za dobijanje ili modifikaciju određenih proizvoda, kao i za različite vidove usluga (npr., korišćenje mikroorganizama za prečišćavanje otpadnih voda).
|
 TEMA BROJA - MOLEKULARNA BIOLOGIJA TEMA BROJA - MOLEKULARNA BIOLOGIJA
Daleki istok
Iskustva istoka
Krajem osamdesetih godina prošlog veka pojačani su kontakti Kine i zapada na polju molekularne biologije. U Šangaju je postojao Institut za biologiju ćelija ali u to vreme gotovo da nije bilo opreme za istaraživanja pa je sve što je bilo potrebno za laboratorije doneto iz Nemačke. U međuvremenu prilike su se znatno promenile.
Kineski naučnik Hsien Vu je, početkom tridesetih godina 20. veka, izložio svoju teoriju o proteinskoj strukturi koja se skoro u potpunosti poklapa sa saznanjima drugih naučnika decenijama kasnije. Posle velikih dostignuća Hsien Vua i njegovih studenata, dalji napredak je biti ometen invazijom Japana, 1937. godine.
|
 TEMA BROJA - MOLEKULARNA BIOLOGIJA TEMA BROJA - MOLEKULARNA BIOLOGIJA
ISTRAŽIVANJA
Nafta za ishranu
Mikrobi koji rastvaraju naftu i petrolej raznovrsniji su nego što se prvobitno mislilo, što nagoveštava da su ugljovodonici korišćeni kao izvor energije na početku Zemljine istorije. Ovi mikrobi mogu da promene sastav nafte i prirodnog gasa, i da kontrolišu oslobađanje određenih štetnih gasova. Razumevanje uloge mikroba u konzumiranju ugljovodonika stoga može da pomogne u proceni kakva je njihova uloga u prirodnoj kontroli klimatskih promena.
Naučnici su identifikovali posebne simbioze između arheja i bakterija koje su u stanju da konzumiraju štetni gas metan pre nego što uspe da pobegne iz sedimenata u okeanu. Druge otkrivene vrste doprinose lečenju biosfere ili čišćenju podzemnih voda zagađenih naftom.
|
PRIČA SA NASLOVNE STRANE PRIČA SA NASLOVNE STRANE
Mikrobiologija
Ideja o postojanju mikrobiološkog života javila se u 6. veku p. n.e. u Kini kada se pominju okom nevidljiva stvorenja koja žive na zemlji, u vodi , vazduhu i vatri . Rimljanin Markus Terencijus Varo pisao je da ne treba živeti u blizini močvara zato što tamo vrvi od stvorenja koja se ne mogu videti a koja lebde u vazduhu i ulaze u ljude kroz nos i usta i prouzrokuju teške bolesti . Godine 1546. Đirolamo Frakastoro tvrdio je da su sve epidemije prouzrokovane česticama sitnim kao najsitnije semenje. Prvi dokazi nastali su tek kada je 1676. Holanđanin Anton van Levenhok posmatrao mikroorganizme pomoću mikroskopa kojeg je sam napravio . Od tada do danas mikrobiologija se razvila u naučnu disciplinu kojoj je nemoguće nazreti granice
|

|
 ČASOPIS PLANETA Br 45 ČASOPIS PLANETA Br 45
SARADNICI NA BROJU
Jozef Baruhović, Dalibor Čevizović, Milan Dimitrijević, Milan Đurić, Filip Franeta, Ibrahim Hadžić, Mirko Jakovljević, Branka Jakšić, Ilijana Jakšić, Zoran Janjušević, Vladimir Jovanović, Oliver Klajn, Nadežda Krstić, Jelisaveta Lalić, Borka Marinković, Mirjana Lukić, Vladimir Milojević, Žaneta Miljanić, Darko Mladenović, Ilja Slani, Mićo Tatalović, Miomir Tomić, Gordana Tomljenović, Snežana Šarboh, Zdenko Štromar
Direktor: Milan Knežević
Glavni i odgovorni urednik: Aleksandar Gaon
Pomoćnik glavnog urednika: Miloslav Rajković
Likovno-grafički urednik: Branka Savković
Fotografije: Rade Krstinić
Internet : Dragan Bogdanović
DISTRIBUCIJA: Global Press d.o.o, Beograd, Žorža Klemansoa 24, 011/276-4538 i 276-9301
ŠTAMPA: "Batatisak”, Beograd, Miloša Savkovića 4-6, 011/38 -20 -333
|
|
|
| » Pratite nas |
 |
 |
|
» Prijatelji Planete |
 |
Sredinom septembra, prateći domete tehnologije, prvi broj našeg lista našao se na računarskoj mreži, u digitalizovanom obliku, zajedno sa još deset prethodno izdatih brojeva. Svi oni koji se zanimaju za sadržaje koje “Planeta” objavljuje a koji zbog različitih razloga nisu u mogućnosti da list nađu na kioscima od sada ga mogu čitati na adresi
 http://planeta.
digitalnikiosk.com/
|
|

|
|

